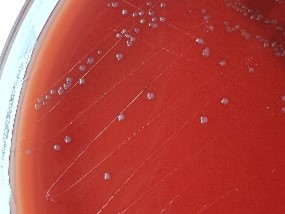
Colonias de Streptococcus suis de Joe Rubin

Streptococcus suis pertenece a la familia Streptococcaceae. Es una bacteria Gram positiva, anaerobia facultativa, inmóvil, con forma esférica o de coco y rodeada de una cápsula; se suele encontrar agrupada formando cadenas de dos (diplococos) o más bacterias, pero también de forma aislada.
La bacteria es hemolítica, pudiendo variar el tipo de hemólisis en función del medio de cultivo utilizado para su crecimiento; así, S. suis presenta α-hemólisis cuando crece en medios de cultivo con sangre de cordero, pero también puede presentar β-hemólisis, normalmente en medios de cultivo con sangre de caballo.
En función de los polisacáridos capsulares se reconocen al menos 35 serotipos con virulencia variable. El serotipo 2 es el que se aísla con mayor frecuencia en los casos clínicos de cerdos y humanos, pero también se pueden aislar otros, como el 1, 4, 14 y 16.
Viabilidad, propagación y transmisión
Reservorio
Las amígdalas, las vías respiratorias superiores y, en menor medida, la mucosa genital de porcino.
Hospedadores
Porcinos, bovinos, ovinos, caprinos, felinos, cánidos, equinos, conejos, aves y humanos.
Dosis Infectiva Mínima (DIM)
Se desconoce en la actualidad.
Supervivencia ambiental
Puede sobrevivir en las heces aproximadamente una semana y en las canales o cadáveres de los cerdos varias semanas. También, en las moscas hasta una semana y en el polvo algunas horas, especialmente en ambientes húmedos y fríos.
Además, puede sobrevivir en agua a 60 ºC hasta 10 min y a 50 ºC hasta 2 horas.
Formas de resistencia
No presenta formas de resistencia.
Mecanismo de propagación y transmisión
La transmisión al hombre se produce principalmente por la inoculación accidental o por la contaminación de heridas con herramientas, superficies o animales contaminados; por contacto directo y mucoso con cerdos o carne contaminada; por la ingesta de carne de cerdo escasamente cocinada y no se descarta la posible transmisión por la inhalación de bioaerosoles.
Es un microorganismo patógeno o comensal principalmente de los cerdos. Los casos en humanos son poco frecuentes y suelen ser una zoonosis de origen laboral por contacto con cerdos o jabalís enfermos o portadores asintomáticos.
Los artrópodos (moscas) y las aves facilitan su dispersión y transmisión.
Vías de entrada
Parenteral. Dérmica. Mucosa. Digestiva. Respiratoria (sospechada).
Distribución geográfica
Mundial.
Efectos sobre la salud
Grupo de riesgo
2
(Ver Anexo II RD 664/1997 )Infección
La meningitis aguda purulenta es la manifestación clínica más frecuente, normalmente cursa con síntomas transitorios, al principio, similares a los de la influenza y después con los característicos de la meningitis como: dolor intenso de cabeza, fiebre, vértigo, náuseas, vómitos, rigidez de cuello y confusión mental. En más del 50 % de los casos pueden persistir secuelas neurológicas (hipoacusia, ataxia, lesión vestibular). La pérdida auditiva es de tipo neurosensorial y puede ser profunda, aunque algunos pacientes mejoran con el tiempo.
También, en raras ocasiones, puede darse una infección sistémica, endocarditis, septicemia, shock tóxico, gastroenteritis, uveítis y neumonía.
La mortalidad de la meningitis por S. suis es baja, del 5 % al 9 %, pero, en caso de shock séptico, puede ser superior al 80 %.
Efectos alérgicos (Ver Anexo II RD 664/1997 ) / (Ver Allergen )
No se han descrito
Efectos tóxicos (Ver Anexo II RD 664/1997 )
S. suis puede producir toxinas que contribuyen a su patogenicidad, entre las que se incluye la hemolisina suilisina (SLY) con capacidad citolítica o citotóxica (1) (5).
Efectos cancerígenos (Ver International Agency for Research On Cancer - IARC )
No se han descrito
Efectos en la maternidad
No se han descrito
Enfermedad
| CIE-10 | Nombre | Enfermedad de Declaración Obligatoria |
|---|---|---|
| G00.2 | Meningitis estreptocócica | No. |
Actividades laborales con riesgo
Clasificación Nacional de Actividades Económicas (CNAE)
| CNAE 2009 | Descripción |
|---|---|
| A0141 | Explotación de ganado bovino para la producción de leche |
| A0142 | Explotación de otro ganado bovino y búfalos |
| A0143 | Explotación de caballos y otros equinos |
| A0144 | Explotación de camellos y otros camélidos |
| A0145 | Explotación de ganado ovino y caprino |
| A0146 | Explotación de ganado porcino |
| A0147 | Avicultura |
| A0148 | Otras explotaciones de ganado |
| A0150 | Producción agrícola combinada con la producción ganadera |
| A0162 | Actividades de apoyo a la ganadería |
| A0170 | Caza, captura de animales y servicios relacionados |
| C1011 | Procesado y conservación de carne, excepto volatería |
| C1012 | Procesado y conservación de volatería |
| C1013 | Elaboración de productos cárnicos y de volatería |
| G4611 | Actividades de intermediarios del comercio al por mayor de materias primas agrarias, animales vivos, materias primas textiles y productos semielaborados |
| G4623 | Comercio al por mayor de animales vivos |
| G4632 | Comercio al por mayor de carne, productos cárnicos; pescado y productos del pescado |
| G4722 | Comercio al por menor de carne y productos cárnicos |
| G4776 | Comercio al por menor de flores, plantas, fertilizantes, animales de compañía y alimentos para estos |
| H4941 | Transporte de mercancías por carretera |
| N7500 | Actividades veterinarias |
| S9141 | Actividades de los jardines botánicos y los parques zoológicos |
Clasificación Nacional de Ocupaciones (CNO)
| CNO 2011 | Descripción |
|---|---|
| 2130 | Veterinarios |
| 2210 | Profesores de universidades y otra enseñanza superior (excepto formación profesional) |
| 2421 | Biólogos, botánicos, zoólogos y afines |
| 3142 | Técnicos agropecuarios |
| 3327 | Ayudantes de veterinaria |
| 5893 | Cuidadores de animales y adiestradores |
| 5993 | Agentes forestales y medioambientales |
| 6201 | Trabajadores cualificados en actividades ganaderas de vacuno |
| 6202 | Trabajadores cualificados en actividades ganaderas de ovino y caprino |
| 6203 | Trabajadores cualificados en actividades ganaderas de porcino |
| 6205 | Trabajadores cualificados en la avicultura y la cunicultura |
| 6209 | Trabajadores cualificados en actividades ganaderas no clasificados bajo otros epígrafes |
| 6430 | Trabajadores cualificados en actividades cinegéticas |
| 7701 | Matarifes y trabajadores de las industrias cárnicas |
| 7836 | Curtidores y preparadores de pieles |
| 8155 | Operadores de máquinas para tratar pieles y cuero |
| 8160 | Operadores de máquinas para elaborar productos alimenticios, bebidas y tabaco |
| 9520 | Peones ganaderos |
| 9530 | Peones agropecuarios |
Prevención y control
Desinfectantes
Hipoclorito sódico al 1 %, glutaraldehído al 2 %, etanol al menos al 70 %, yodo al 0,16 %, ácido peracético al 2 %, peróxido de hidrógeno al 3-6 %, compuestos de amonio cuaternario y compuestos fenólicos.
Inactivación física
Inactivación por calor húmedo a 121 ºC durante al menos 15 minutos y por calor seco a 170 ºC durante al menos una hora.
Antimicrobianos
Penicilina, amoxicilina, ampicilina, cefalosporinas de tercera generación (ceftriaxona), vancomicina y clindamicina.
Se han descrito resistencias a algunos antibióticos.
Vacunación
No disponible
Medidas preventivas generales
Evitar o reducir el uso de herramientas cortantes o punzantes; en caso necesario, utilizarlas con las debidas protecciones y precauciones. Evitar situaciones estresantes en la cría, manipulación y transporte de los animales para evitar lesiones o mordeduras.
Adecuadas medidas de higiene: lavado de manos con agua y jabón al finalizar la jornada laboral, después de quitarse los guantes y tras el contacto con elementos o animales contaminados. Limpieza y desinfección de cortes, arañazos o heridas en la piel, evitar el contacto de las mismas con elementos o animales contamina-dos. Cubrir las heridas con apósitos estériles e impermeables. Utilizar ropa de tra-bajo y equipos de protección individual de cierta resistencia mecánica.
Control sanitario de los animales y de los alimentos. Evitar comer carne de cerdo poco cocinada (cocinar la carne durante al menos 10 minutos a más de 60 ºC).
Mantener los locales de trabajo, de cría y estabulación de los animales, y los equipos y herramientas de trabajo en condiciones adecuadas de ventilación, limpieza y desinfección.
Manipulación y eliminación adecuada de residuos (heces, cadáveres), según las legislaciones específicas.
Control de vectores, desinsectación y desratización.
Precauciones en centros sanitarios
En hospitales, centros sanitarios y veterinarios, adoptar las Precauciones Estándar (10).
EPI
Protección de las manos: guantes de protección frente a microorganismos en caso de contacto o manipulación de materiales potencialmente infecciosos y de cierta resistencia mecánica en caso de riesgo de corte o abrasiones.
Protección respiratoria: mascarillas autofiltrantes tipo FFP2, preferiblemente FFP3, o máscaras con filtro P2 o P3 para operaciones en las que se generen bioaerosoles contaminados.
Protección ocular o facial: gafa de protección de montura universal en caso de riesgo de contacto accidental mano/guante contaminado-ojo, o pantalla de protección facial (símbolo de marcado en montura: 3) en caso de riesgo de exposición a salpicaduras.
Seguridad en laboratorio
Nivel de contención: 2
Los principales riesgos son la inoculación accidental y la exposición a bioaerosoles, gotas o salpicaduras.
Los especímenes o muestras más peligrosas son: secreciones nasofaríngeas, heridas, sangre, heces y secreciones vaginales de cerdos y jabalíes.
Se requieren las prácticas y la contención de un nivel 2 de bioseguridad para realizar cultivos o para manipular muestras o animales infectados. Utilizar cabina de seguridad biológica, cuando se puedan producir bioaerosoles, salpicaduras o se trabaje con grandes cantidades. Se debe evitar o reducir el uso de material cortante o punzante. Además, se deben seguir unas correctas prácticas de higiene, lavado de manos, uso de guantes y ropa de trabajo; así como una eliminación adecuada de residuos.
Bibliografía
- C. López-Mestanza, A. Bolaño-Navarro, A. Sánchez-Sánchez, C. Aldea-Mansilla. Primer caso de shock séptico por Streptococcus suis de posible etiología alimentaria en España. Medicina intensiva. 2016; 40(8): 461-524.
- E. Koch, G. Fuentes, R. Carvajal, R. Palma, V. Aguirre, C. Cruz, R. Henríquez y M. Calvo. Meningitis bacteriana aguda por Streptococcus suis en criadores de cerdos: comunicación de los primeros dos casos en Chile. Rev. chil. infectol. 2013; 30 (5): 557-561.
- J.A. Sáez Nieto. Streptococcus suis: Un patógeno con creciente interés para cerdos y humanos. Centro Nacional de Microbiología. Instituto de Salud Carlos III.
- P. Alarcón. Streptococcus suis. Rev. Chil. Infectol. 2012; 29 (5): 541-542.
- TC. Barnett, JN. Cole, T. Rivera-Hernández, A. Henningham, JC. Paton, V. Nizet, MJ. Walker. Streptococcal toxins: role in pathogenesis and disease. Cellular Microbiology. 2015; 17(12): 1721-1741.
- Institut National de Recherche et de Sécurité. Exposition fortuite à un agent infectieux et conduite à tenir en milieu de travail, EFICATT. Streptococcus suis. 2014.
- Institut National de Recherche et de Sécurité. INRS. Base dÓBservation des Agents Biologique. Streptococcus suis. 2022.
- Instituto Nacional de Seguridad e Higiene en el Trabajo (INSHT). Notas Técnicas de Prevención (NTP) 901. Riesgo biológico: prevención en mataderos.
- Organización Panamericana de la Salud (OPS). ZOONOSIS Y ENFERMEDADES TRANSMISIBLES COMUNES AL HOMBRE Y A LOS ANIMALES. Volumen I. Bacteriosis y micosis. 3ª edición. 2003.
- Servicio Riojano de Salud. Precauciones de aislamiento en centros sanitarios. 2008.
- The Center for Food Security & Public Health. Iowa State University. Zoonotic Streptococcosis. 2020.